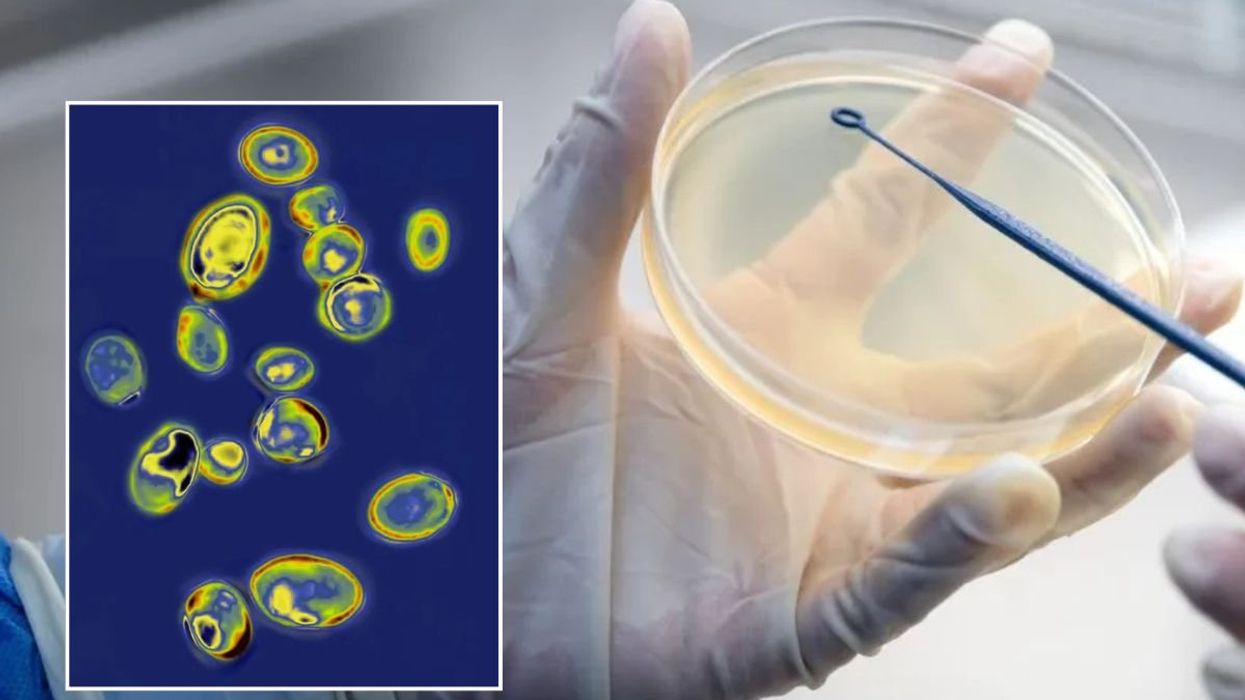
CANDIDA AURIS

'I’m fighting for my reputation and medical licence after blowing the whistle on Covid vaccines'
Cardiologist Dr Aseem Malhotra says he is facing a potential investigation by the medical regulator after publicly questioning the safety data behind mRNA jabs